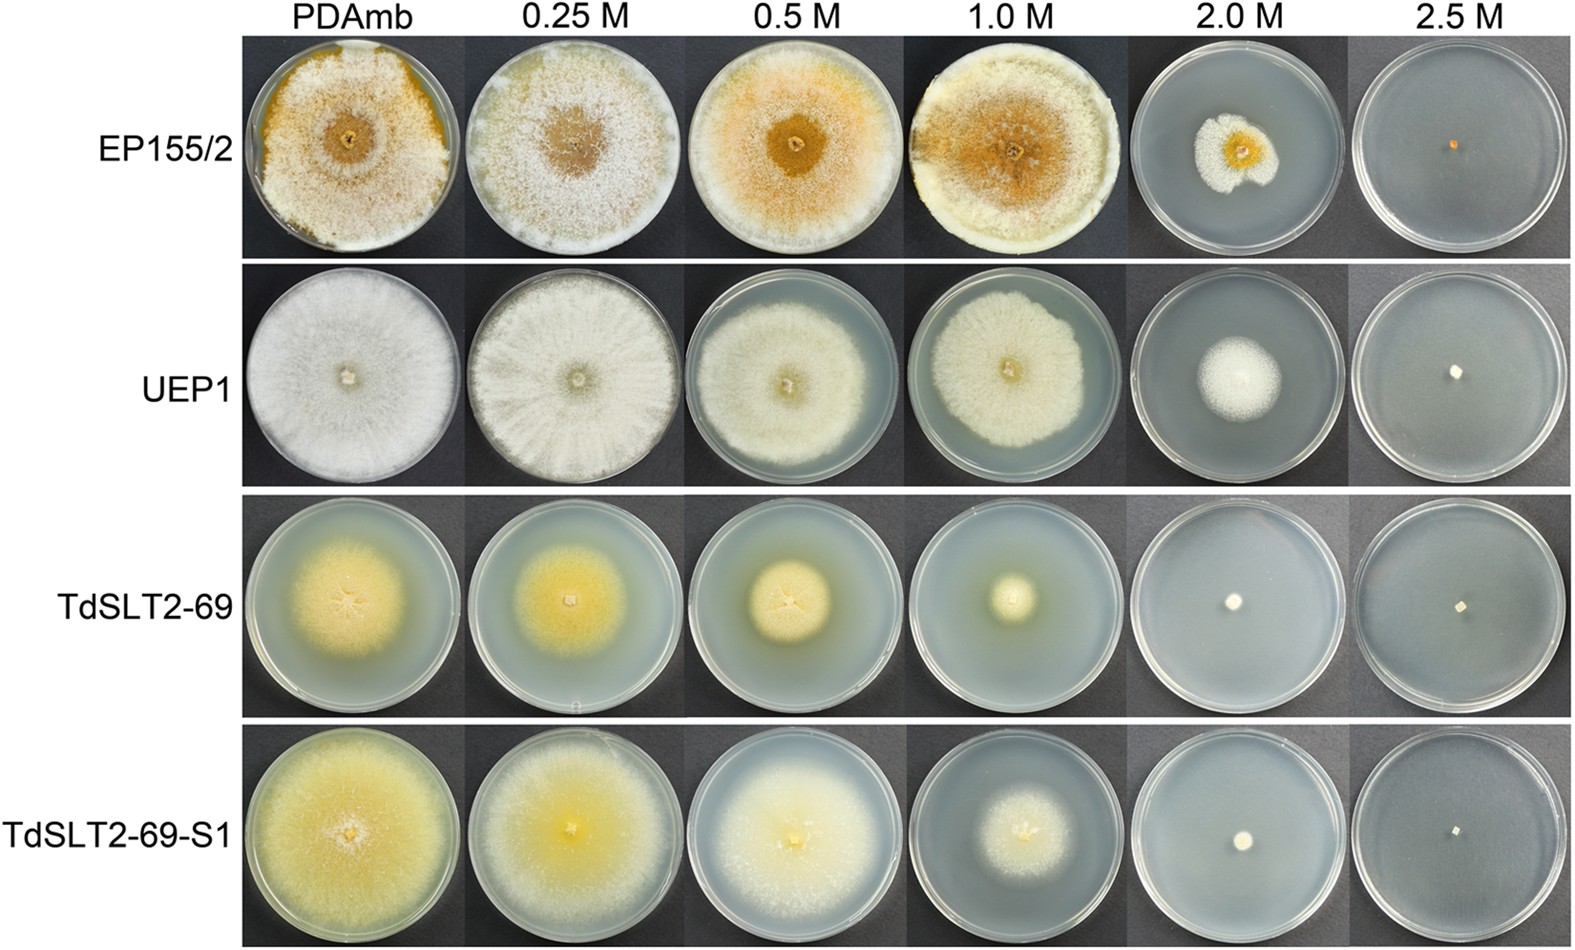
Figure 5

Figure 5
Effect of supplementation with various concentrations of an osmotic stabilizer on fungal growth. Colony morphologies on PDAmb supplemented with corresponding concentrations of sorbitol are shown after 10 d of cultivation. Strains are wild-type EP155/2, UEP1, TdSLT2-69, and the sectored TdSLT2-69 progeny, TdSLT2-69-S1. Note that colonies with the same CpSlt2 mutant background, such as TdSLT2-69 and TdSLT2-69-S1, showed more severe growth defects when cultivated on plates containing 1.0 M sorbitol. On the other hand, wild type and its isogenic hypovirulent UEP1 strains cultivated in the presence and absence of 1.0 M sorbitol were not significantly different.